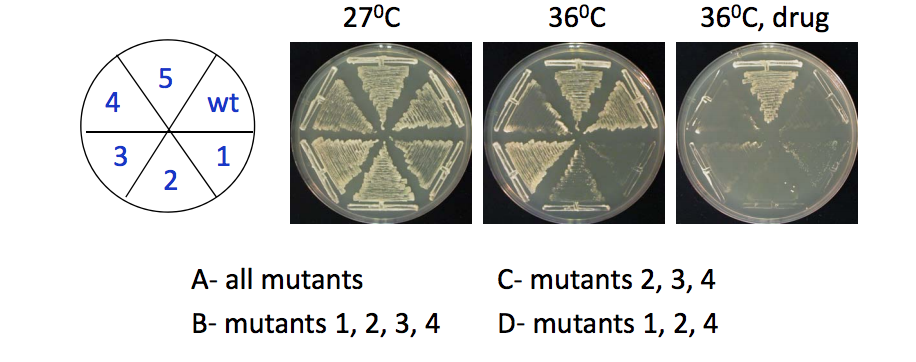

ILOs
What are model organisms?
There are many problems with testing on humans:
Ethics
Complexity - 20,000 genes, many redundancies and introns
Technical - cells not always accessible (e.g. neurons), expensive, time consuming, unstable phenotypes, cell lines
Wellcome Trust: “A model organism is a species that has been widely studied, usually because it is easy to maintain and breed in a laboratory setting and has particular experimental advantages”.
Help understand fundamental mechanisms applicable to more complex systems, including humans
Modern Classical Model Organisms
Each model has advantages and disadvantages
‐ Over the years, tools have been developed to study them
‐ Their genome is now fully sequenced
‐ A few Nobel Prizes (e.g. cell cycle, trafficking, RNAi, etc.)
What makes a good model organism?
1) The biological question
2) Conclusions can be applied to other systems
3) The simplicity or complexity
4) The techniques that can be used and the tools that already exist
5) The cost, time, space requirement, ease of handling, etc.
6) Ethical considerations
The biological question
E.g.: S. pombe to study the mechanisms of cell shape

Biological question continued

E.g.: naked mole‐rat to study the mechanisms of aging
‐ Very long lived (28 years!)
‐ Longevity quotient similar to humans
‐ Reduced incidence of cancer
‐ Why and how..?

Conclusions can be applied to other systems
Gene conservation
Data Handling practice
Your friend works on Protein A and purifies it from the daisy plant. She is able to determine the sequence of the daisy protein and aligns it with similar proteins found in yeast
In yeast, Protein A interacts with Protein B. Your friend discovers that when she replaces yeast Protein A by daisy Protein A inside the yeast, then daisy Protein A does not interact with yeast Protein B. Which amino acid(s) in Protein A may be responsible for its interaction with Protein B?
You may chose 1 or several answers.
Daisy F I L P I R V Y A H E V P T L W Y R
Yeast F I E P I R V Y A H E V V T L W Y R 1 2 3 4
A ‐ only 1
B ‐ only 4
C ‐ 1 and 3
D ‐ 1 or 3
E ‐ 2 and 3
F ‐ 2 or 3
Answer: E and F
Feedback: the daisy protein cannot play its normal function in yeast because it does not have amino acids 2 and 3 that the daisy protein has. Thus, amino acids 2 and amino acid 3 are apparently important for the interaction. This experiment does not allow to distinguish which of the two is important (both may be).
Simplicity vs. Complexity - cell biology

You can see how much easier to follow the microtubules are to see in Yeast
Sometimes you have to study complexity too
Simplicity vs. Complexity - unicellular or multicellular organism?
Single celled:
Single cell carries out all the life processes
Divides
Cell body exposed to environment on all sides
Multicellular:
Different cells specialised to play different functions
Differentiated cells lose the ability to divide
Extra functions needed (e.g. cell-cell communication)
Outer cells are exposed and protect inner cells that are devoted to other functions
Simplicity vs. Complexity - Gene redundancy

2 genes that play the same function and can replace each other are said to be redundant.
In a KO, an absence of phenotype may be due to gene redundancy.
‐ Redundancy is due to evolutionary gene duplication
‐ Some organisms show less redundancy than others
(little frog is a regular diploid)

Synbio
“Biologists Create Synthetic Bacteria With No Extra Genes” http://www.sciencemag.org/news/2016 /03/synthetic‐microbe‐lives‐less‐500‐ genes ‐ Called Syn 3.0 ‐ Does not exist in the wild ‐ No duplicated gene ‐ 473 genes, all essential ‐ 149 genes of unknown function!
Ethical considerations
GMOs (or “genetically modified organisms”) are living organisms whose genetic material has been artificially manipulated in a laboratory through genetic engineering.
Ethical considerations Replacement, Reduction, Refinement
What can we do with model organisms?
Chemical Screen
E.g.: can we find a chemical that affects (or rescues!) the development of embryos?
to test systematically on a large scale

Genetic screens - forward genetics (phenotype to genotype)

E.g.: what genes are responsible for the rod shape of S. pombe?

Data handling practice
You have carried out a genetic screen in a species of frog to try and identify genes that affect cell division and may therefore be involved in cancer. You have identified a new gene of unknown function. Which of the following is the most sensible next step in order to get clues about the function?
A. Purifying the protein product and determining its structure
B. Screening for small molecules that perturb gene function
C. Scan sequence databases for similar sequences
D. Mutating the gene to find out what happens
Answer: C
All would help characterise the function of the gene. But the fastest, easiest and cheapest option is to search a collection of known gene and protein sequences (aka BLAST). The clues generated from such searches typically help the investigator in future, direct experimental studies. E.g.: identify a domain or an orthologue in a different organism
Genetic screens - reverse genetics (genotype to phenotype)
Genetic Manipulation

Knock out (KO): DNA is deleted - no protein at all
Knock down (KD): - mRNA is partially degraded, some protein left
Mutant: Gene is mutated - protein is there but not fully functional
Conditional Mutant: Gene is mutated but phenotype only shows under certain condition
Data Handling Practice
In yeast, temperature‐sensitive (ts) mutants are a type of conditional mutants that show a phenotype at high temperatures. The wild‐type (wt) and 5 ts mutants (1 to 5) were streaked on different media containing either nothing or an anti‐microtubule drug, incubated at 2 different temperatures and let to grow for a few days. Which mutants are definitely sensitive to the anti‐microtubule drug?
Answer: C - mutants 2,3,4
WT grows at any temperature and is sensitive to the drug (positive control= the drug works). Nothing can be concluded for ts1 because it does not grow at 36oC, even with no drug (negative control= the drug does not work). ts5 is not sensitive to the drug because it grows in the presence of the drug, even at 36oC. ts2, 3 and 4 may grow less at 36oC but grow even less in the presence of the drug (compare 36oC and 36oC + drug).
Is there a perfect model organism?
Data Handling practice
Which of the following statements are true?
1‐ I love S. pombe
2‐ S. pombe is the best yeast
3‐ S. pombe does not have cilia, and cannot, therefore, be used to study mechanisms associated with ciliogenesis
4‐ Only S. pombe can be used to study cell shape
Answer: 1
There is no such thing as an absolute model organism. The scientific context matters. Model organisms can be used to study FUNDAMENTAL processes, that may used during ciliogenesis
Nobody’s perfect, not even S. pombe
Pros:
“minimal eukaryote model”
‐ Cheap, fast and easy
‐ Ethical
‐ V. small genomes
‐ Community tools exist
‐ Non pathogenic
Cons:
Is not human…!
‐ Missing some of the characteristics of mammalian cells (differentiation, movement, disease)
‐ Has a cell wall